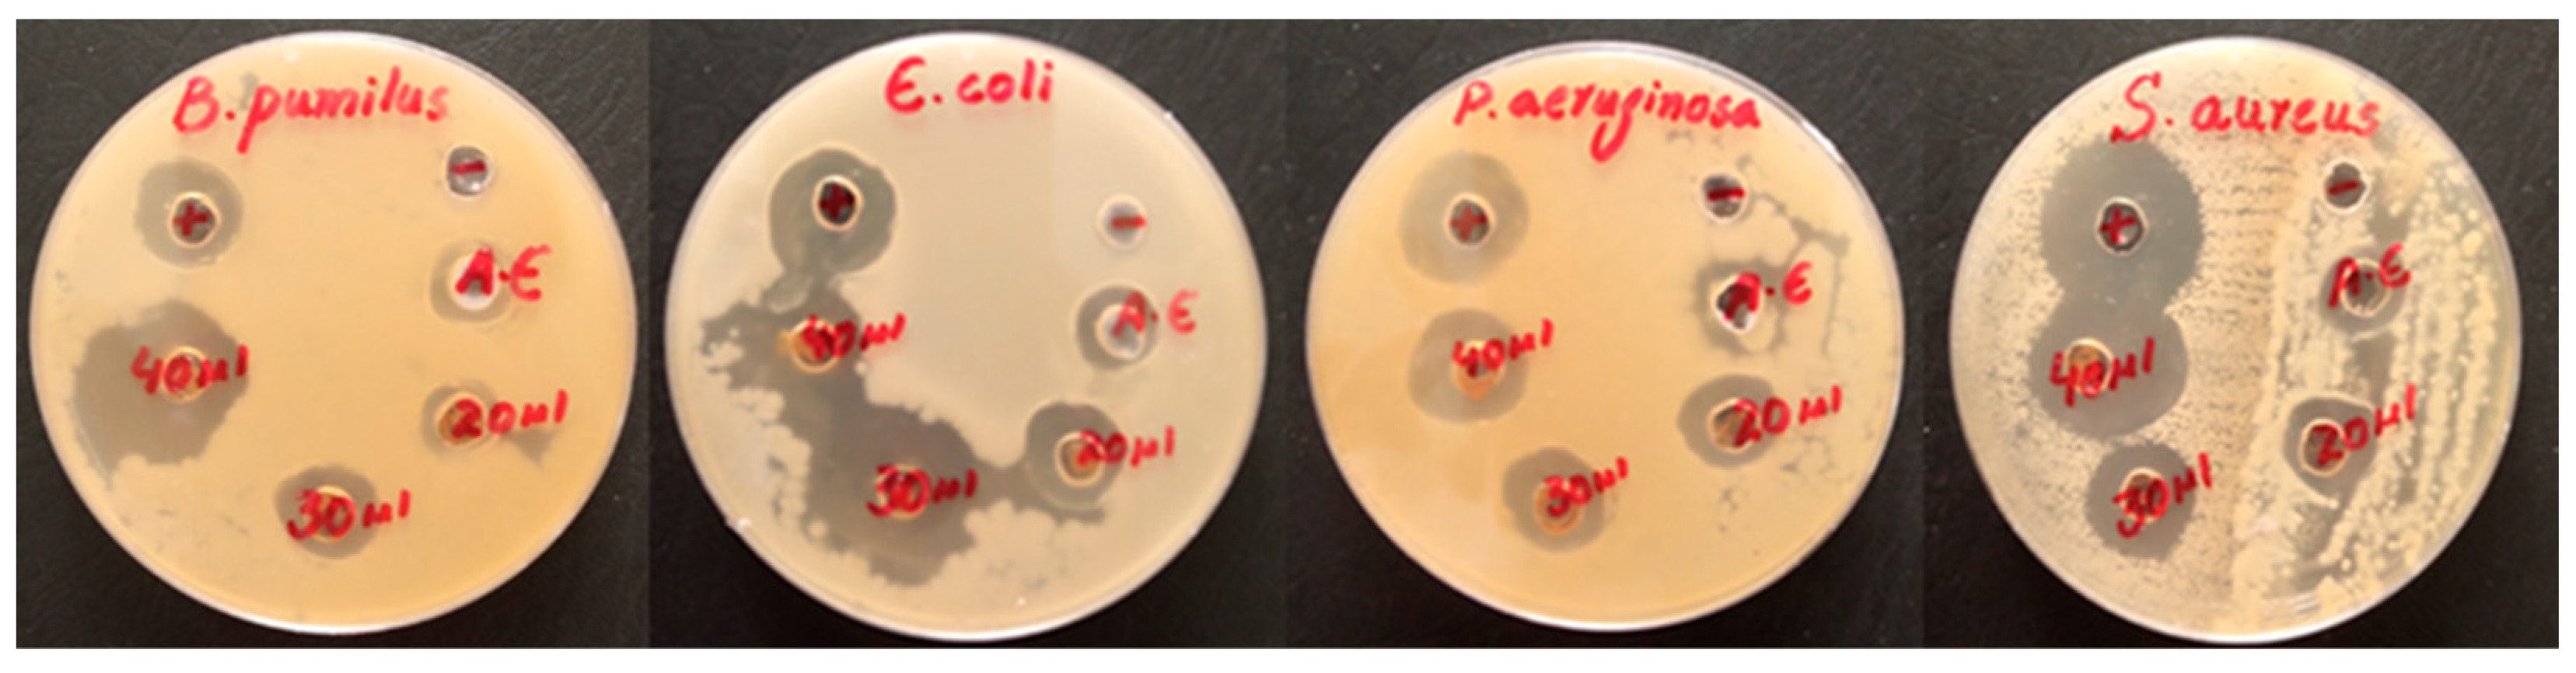
Molecules 28 03403 g006

Biofabrication of Fe3O4 Nanoparticles from Spirogyra hyalina and Ajuga bracteosa and Their Antibacterial Applications
Abstract
1. Introduction
2. Results
2.1. Characterization of Iron Oxide NPs
2.1.1. UV-Vis Analysis of Fe3O4 NPs
2.1.2. FTIR Analysis of Fe3O4 NPs
2.1.3. X-ray Diffraction of Fe3O4 NPs
2.1.4. Scanning Electron Microscopy
2.1.5. EDX Analysis of Fe3O4 NPs
2.2. In Vitro Studies
2.2.1. Antibacterial Activity
2.2.2. Antioxidant Activity
3. Materials and Methods
3.1. Preparation of Algal and Plant Extract
3.2. Green Biofabrication of Algal- and Plant-Based Iron Oxide NPs
3.3. Characterization of Fe3O4 NPs
3.4. Measuring Antibacterial Activity
3.5. Antioxidant Potential
4. Conclusions
Author Contributions
Funding
Institutional Review Board Statement
Informed Consent Statement
Data Availability Statement
Acknowledgments
Conflicts of Interest
Sample Availability
References
- Wang, Z.; Liu, X.; Ni, S.-Q.; Zhuang, X.; Lee, T. Nano zero-valent iron improves anammox activity by promoting the activity of quorum sensing system. Water Res. 2021, 202, 117491. [Google Scholar] [CrossRef] [PubMed]
- Chen, Y.; Li, J.; Lu, J.; Ding, M.; Chen, Y. Synthesis and properties of poly (vinyl alcohol) hydrogels with high strength and toughness. Polym. Test. 2022, 108, 107516. [Google Scholar] [CrossRef]
- Yang, K.; Geng, Q.; Luo, Y.; Xie, R.; Sun, T.; Wang, Z.; Qin, L.; Zhao, W.; Liu, M.; Li, Y. Dysfunction of FadA-cAMP signalling decreases Aspergillus flavus resistance to antimicrobial natural preservative Perillaldehyde and AFB1 biosynthesis. Environ. Microbiol. 2022, 24, 1590–1607. [Google Scholar] [CrossRef] [PubMed]
- Shen, L.; Li, B.; Qiao, Y. Fe3O4 nanoparticles in targeted drug/gene delivery systems. Materials 2018, 11, 324. [Google Scholar] [CrossRef]
- Vallabani, N.S.; Singh, S. Recent advances and future prospects of iron oxide nanoparticles in biomedicine and diagnostics. 3 Biotech 2018, 8, 279. [Google Scholar] [CrossRef]
- Andrade, R.G.; Veloso, S.R.; Castanheira, E.M. Shape anisotropic iron oxide-based magnetic nanoparticles: Synthesis and biomedical applications. Int. J. Mol. Sci. 2020, 21, 2455. [Google Scholar] [CrossRef]
- Sathiyaseelan, A.; Saravanakumar, K.; Mariadoss, A.V.A.; Wang, M.-H. Antimicrobial and wound healing properties of FeO fabricated chitosan/PVA nanocomposite sponge. Antibiotics 2021, 10, 524. [Google Scholar] [CrossRef]
- Lu, J.; Chen, Y.; Ding, M.; Fan, X.; Hu, J.; Chen, Y.; Li, J.; Li, Z.; Liu, W. A 4arm-PEG macromolecule crosslinked chitosan hydrogels as antibacterial wound dressing. Carbohydr. Polym. 2022, 277, 118871. [Google Scholar] [CrossRef]
- Montiel Schneider, M.G.; Martín, M.J.; Otarola, J.; Vakarelska, E.; Simeonov, V.; Lassalle, V.; Nedyalkova, M. Biomedical applications of iron oxide nanoparticles: Current insights progress and perspectives. Pharmaceutics 2022, 14, 204. [Google Scholar] [CrossRef]
- Shi, Q.; Pu, S.; Yang, X.; Wang, P.; Tang, B.; Lai, B. Enhanced heterogeneous activation of peroxymonosulfate by boosting internal electron transfer in a bimetallic Fe3O4-MnO2 nanocomposite. Chin. Chem. Lett. 2022, 33, 2129–2133. [Google Scholar] [CrossRef]
- Patiño-Ruiz, D.A.; Meramo-Hurtado, S.I.; González-Delgado, Á.D.; Herrera, A. Environmental sustainability evaluation of iron oxide nanoparticles synthesized via green synthesis and the coprecipitation method: A comparative life cycle assessment study. ACS Omega 2021, 6, 12410–12423. [Google Scholar] [CrossRef] [PubMed]
- Wang, Z.; Dai, L.; Yao, J.; Guo, T.; Hrynsphan, D.; Tatsiana, S.; Chen, J. Improvement of Alcaligenes sp. TB performance by Fe-Pd/multi-walled carbon nanotubes: Enriched denitrification pathways and accelerated electron transport. Bioresour. Technol. 2021, 327, 124785. [Google Scholar] [CrossRef] [PubMed]
- Sheikhpour, M.; Arabi, M.; Kasaeian, A.; Rabei, A.R.; Taherian, Z. Role of Nanofluids in Drug Delivery and Biomedical Technology: Methods and Applications. Nanotechnol. Sci. Appl. 2020, 13, 47–59. [Google Scholar] [CrossRef] [PubMed]
- Zhang, K.-Q.; Deng, Q.-F.; Luo, J.; Gong, C.-L.; Chen, Z.-G.; Zhong, W.; Hu, S.-Q.; Wang, H.-F. Multifunctional Ag (I)/CAAA-amidphos complex-catalyzed asymmetric [3 + 2] cycloaddition of α-substituted acrylamides. ACS Catal. 2021, 11, 5100–5107. [Google Scholar] [CrossRef]
- Dadfar, S.M.; Roemhild, K.; Drude, N.I.; von Stillfried, S.; Knüchel, R.; Kiessling, F.; Lammers, T. Iron oxide nanoparticles: Diagnostic, therapeutic and theranostic applications. Adv. Drug Deliv. Rev. 2019, 138, 302–325. [Google Scholar] [CrossRef]
- Seddighi, N.S.; Salari, S.; Izadi, A.R. Evaluation of antifungal effect of iron-oxide nanoparticles against different Candida species. IET Nanobiotechnol. 2017, 11, 883–888. [Google Scholar] [CrossRef]
- Neupane, B.P.; Chaudhary, D.; Paudel, S.; Timsina, S.; Chapagain, B.; Jamarkattel, N.; Tiwari, B.R. Himalayan honey loaded iron oxide nanoparticles: Synthesis, characterization and study of antioxidant and antimicrobial activities. Int. J. Nanomed. 2019, 14, 3533–3541. [Google Scholar] [CrossRef]
- Arias, L.S.; Pessan, J.P.; Vieira, A.P.M.; Lima, T.M.T.d.; Delbem, A.C.B.; Monteiro, D.R. Iron oxide nanoparticles for biomedical applications: A perspective on synthesis, drugs, antimicrobial activity, and toxicity. Antibiotics 2018, 7, 46. [Google Scholar] [CrossRef]
- Winkler, H.C.; Notter, T.; Meyer, U.; Naegeli, H. Critical review of the safety assessment of titanium dioxide additives in food. J. Nanobiotechnol. 2018, 16, 1–19. [Google Scholar] [CrossRef]
- Liu, Y.; Fan, B.; Xu, B.; Yang, B. Ambient-stable polyethyleneimine functionalized Ti3C2Tx nanohybrid corrosion inhibitor for copper in alkaline electrolyte. Mater. Lett. 2023, 337, 133979. [Google Scholar] [CrossRef]
- Liu, Z.; Fan, B.; Zhao, J.; Yang, B.; Zheng, X. Benzothiazole derivatives-based supramolecular assemblies as efficient corrosion inhibitors for copper in artificial seawater: Formation, interfacial release and protective mechanisms. Corros. Sci. 2023, 212, 110957. [Google Scholar] [CrossRef]
- Ou, C.-H.; Pan, Y.-M.; Tang, H.-T. Electrochemically promoted N-heterocyclic carbene polymer-catalyzed cycloaddition of aldehyde with isocyanide acetate. Sci. China Chem. 2022, 65, 1873–1878. [Google Scholar] [CrossRef]
- Chen, H.; Xu, C.; Zhao, F.; Geng, C.; Liu, Y.; Zhang, J.; Kang, Q.; Li, Z. Designing the anti-biofouling surface of an ultrafiltration membrane with a novel zwitterionic poly (aryl ether oxadiazole) containing benzimidazole. Appl. Surf. Sci. 2023, 609, 155447. [Google Scholar] [CrossRef]
- Duan, C.; Deng, H.; Xiao, S.; Xie, J.; Li, H.; Zhao, X.; Han, D.; Sun, X.; Lou, X.; Ye, C. Accelerate gas diffusion-weighted MRI for lung morphometry with deep learning. Eur. Radiol. 2022, 32, 702–713. [Google Scholar] [CrossRef] [PubMed]
- Li, G.; Huang, S.; Li, K.; Zhu, N.; Zhao, B.; Zhong, Q.; Zhang, Z.; Ge, D.; Wang, D. Near-infrared responsive Z-scheme heterojunction with strong stability and ultra-high quantum efficiency constructed by lanthanide-doped glass. Appl. Catal. B Environ. 2022, 311, 121363. [Google Scholar] [CrossRef]
- Benelli, G. Green synthesis of nanomaterials. Nanobiotechnol. Plant Protect. 2019, 9, 1275. [Google Scholar] [CrossRef]
- Jain, A.S.; Pawar, P.S.; Sarkar, A.; Junnuthula, V.; Dyawanapelly, S. Bionanofactories for green synthesis of silver nanoparticles: Toward antimicrobial applications. Int. J. Mol. Sci. 2021, 22, 11993. [Google Scholar] [CrossRef]
- Khan, M.J.; Shameli, K.; Sazili, A.Q.; Selamat, J.; Kumari, S. Rapid green synthesis and characterization of silver nanoparticles arbitrated by curcumin in an alkaline medium. Molecules 2019, 24, 719. [Google Scholar] [CrossRef]
- Hano, C.; Abbasi, B.H. Plant-based green synthesis of nanoparticles: Production, characterization and applications. Biomolecules 2021, 12, 31. [Google Scholar] [CrossRef]
- Mukherjee, A.; Sarkar, D.; Sasmal, S. A review of green synthesis of metal nanoparticles using algae. Front. Microbiol. 2021, 12, 693899. [Google Scholar] [CrossRef]
- Kiwumulo, H.F.; Muwonge, H.; Ibingira, C.; Lubwama, M.; Kirabira, J.B.; Ssekitoleko, R.T. Green synthesis and characterization of iron-oxide nanoparticles using Moringa oleifera: A potential protocol for use in low and middle income countries. BMC Res. Notes 2022, 15, 1–8. [Google Scholar] [CrossRef] [PubMed]
- Takano, T.; Higuchi, S.; Ikegaya, H.; Matsuzaki, R.; Kawachi, M.; Takahashi, F.; Nozaki, H. Identification of 13 Spirogyra species (Zygnemataceae) by traits of sexual reproduction induced under laboratory culture conditions. Sci. Rep. 2019, 9, 1–11. [Google Scholar] [CrossRef] [PubMed]
- Sulfahri Amin, M.; Sumitro, S.B.; Saptasari, M. Bioethanol production from algae Spirogyra hyalina using Zymomonas mobilis. Biofuels 2016, 7, 621–626. [Google Scholar] [CrossRef]
- Putra, A.W. Biofiltration Efficiency of Algae Spirogyra hyalina to Reduce Salinity of Sea Water. Int. J. Appl. Biol. 2017, 1, 9–13. [Google Scholar] [CrossRef]
- Kumar, J.N.; Oommen, C. Removal of heavy metals by biosorption using freshwater alga Spirogyra hyalina. J. Environ. Biol. 2012, 33, 27. [Google Scholar] [PubMed]
- Hussain, M.; Bibi, Y.; Raja, N.I.; Iqbal, M.; Aslam, S.; Tahir, N.; Imran, M.; Iftikhar, A. A review of therapeutic potential of Ajuga bracteosa: A critically endangered plant from Himalaya. J. Coast. Life Med. 2016, 4, 918–924. [Google Scholar]
- Kayani, W.K.; Dilshad, E.; Ahmed, T.; Ismail, H.; Mirza, B. Evaluation of Ajuga bracteosa for antioxidant, anti-inflammatory, analgesic, antidepressant and anticoagulant activities. BMC Complement. Alternat. Med. 2016, 16, 1–13. [Google Scholar] [CrossRef]
- Rubnawaz, S.; Okla, M.K.; Akhtar, N.; Khan, I.U.; Bhatti, M.Z.; Duong, H.-Q.; El-Tayeb, M.A.; Elbadawi, Y.B.; Almaary, K.S.; Moussa, I.M. Antibacterial, antihemolytic, cytotoxic, anticancer, and antileishmanial effects of Ajuga bracteosa transgenic plants. Plants 2021, 10, 1894. [Google Scholar] [CrossRef]
- Afreen, A.; Ahmed, R.; Mehboob, S.; Tariq, M.; Alghamdi, H.A.; Zahid, A.A.; Ali, I.; Malik, K.; Hasan, A. Phytochemical-assisted biosynthesis of silver nanoparticles from Ajuga bracteosa for biomedical applications. Mater. Res. Express 2020, 7, 075404. [Google Scholar] [CrossRef]
- El-Sheekh, M.M.; El-Kassas, H.Y.; Shams El-Din, N.G.; Eissa, D.I.; El-Sherbiny, B.A. Green synthesis, characterization applications of iron oxide nanoparticles for antialgal and wastewater bioremediation using three brown algae. Int. J. Phytoremed. 2021, 23, 1538–1552. [Google Scholar] [CrossRef]
- Demirezen, D.A.; Yıldız, Y.Ş.; Yılmaz, Ş.; Yılmaz, D.D. Green synthesis and characterization of iron oxide nanoparticles using Ficus carica (common fig) dried fruit extract. J. Biosci. Bioeng. 2019, 127, 241–245. [Google Scholar] [CrossRef] [PubMed]
- Niraimathee, V.; Subha, V.; Ravindran, R.E.; Renganathan, S. Green synthesis of iron oxide nanoparticles from Mimosa pudica root extract. Int. J. Environ. Sustain. Dev. 2016, 15, 227–240. [Google Scholar] [CrossRef]
- Lakshminarayanan, S.; Shereen, M.F.; Niraimathi, K.; Brindha, P.; Arumugam, A. One-pot green synthesis of iron oxide nanoparticles from Bauhinia tomentosa: Characterization and application towards synthesis of 1, 3 diolein. Sci. Rep. 2021, 11, 1–13. [Google Scholar] [CrossRef] [PubMed]
- Kumar, V.G.V.; Prem, A.A. Green Synthesis and Characterization of Iron Oxide Nanoparticles Using Phyllanthus Niruri Extract. Orient. J. Chem. 2018, 34, 2583–2589. [Google Scholar]
- Qasim, S.; Zafar, A.; Saif, M.S.; Ali, Z.; Nazar, M.; Waqas, M.; Haq, A.U.; Tariq, T.; Hassan, S.G.; Iqbal, F. Green synthesis of iron oxide nanorods using Withania coagulans extract improved photocatalytic degradation and antimicrobial activity. J. Photochem. Photobiol. B Biol. 2020, 204, 111784. [Google Scholar] [CrossRef]
- Aisida, S.O.; Madubuonu, N.; Alnasir, M.H.; Ahmad, I.; Botha, S.; Maaza, M.; Ezema, F.I. Biogenic synthesis of iron oxide nanorods using Moringa oleifera leaf extract for antibacterial applications. Appl. Nanosci. 2020, 10, 305–315. [Google Scholar] [CrossRef]
- Liu, H.; Li, P.; Lu, B.; Wei, Y.; Sun, Y. Transformation of ferrihydrite in the presence or absence of trace Fe (II): The effect of preparation procedures of ferrihydrite. J. Solid State Chem. 2009, 182, 1767–1771. [Google Scholar] [CrossRef]
- Yew, Y.P.; Shameli, K.; Miyake, M.; Kuwano, N.; Bt Ahmad Khairudin, N.B.; Bt Mohamad, S.E.; Lee, K.X. Green synthesis of magnetite (Fe3O4) nanoparticles using seaweed (Kappaphycus alvarezii) extract. Nanoscale Res. Lett. 2016, 11, 1–7. [Google Scholar] [CrossRef]
- Zhang, X.-L.; Zhao, X.; Liu, Z.-B.; Shi, S.; Zhou, W.-Y.; Tian, J.-G.; Xu, Y.-F.; Chen, Y.-S. Nonlinear optical and optical limiting properties of graphene oxide–Fe3O4 hybrid material. J. Opt. 2011, 13, 075202. [Google Scholar] [CrossRef]
- Basavegowda, N.; Magar, K.B.S.; Mishra, K.; Lee, Y.R. Green fabrication of ferromagnetic Fe 3 O 4 nanoparticles and their novel catalytic applications for the synthesis of biologically interesting benzoxazinone and benzthioxazinone derivatives. N. J. Chem. 2014, 38, 5415–5420. [Google Scholar] [CrossRef]
- Bibi, I.; Nazar, N.; Ata, S.; Sultan, M.; Ali, A.; Abbas, A.; Jilani, K.; Kamal, S.; Sarim, F.M.; Khan, M.I. Green synthesis of iron oxide nanoparticles using pomegranate seeds extract and photocatalytic activity evaluation for the degradation of textile dye. J. Mater. Res. Technol. 2019, 8, 6115–6124. [Google Scholar] [CrossRef]
- Venkateswarlu, S.; Rao, Y.S.; Balaji, T.; Prathima, B.; Jyothi, N. Biogenic synthesis of Fe3O4 magnetic nanoparticles using plantain peel extract. Mater. Lett. 2013, 100, 241–244. [Google Scholar] [CrossRef]
- Aruna, V.; Chada, N.; Tejaswini Reddy, M.; Geethikalal, V.; Dornala, K.; Nagendranatha Reddy, C. Plant Synthesized Nanoparticles for Dye Degradation. In Phytonanotechnology; Springer: Berlin/Heidelberg, Germany, 2022; pp. 1–30. [Google Scholar]
- Vasantharaj, S.; Sathiyavimal, S.; Senthilkumar, P.; LewisOscar, F.; Pugazhendhi, A. Biosynthesis of iron oxide nanoparticles using leaf extract of Ruellia tuberosa: Antimicrobial properties and their applications in photocatalytic degradation. J. Photochem. Photobiol. B Biol. 2019, 192, 74–82. [Google Scholar] [CrossRef] [PubMed]
- Bhuiyan, M.S.H.; Miah, M.Y.; Paul, S.C.; Aka, T.D.; Saha, O.; Rahaman, M.M.; Sharif, M.J.I.; Habiba, O.; Ashaduzzaman, M. Green synthesis of iron oxide nanoparticle using Carica papaya leaf extract: Application for photocatalytic degradation of remazol yellow RR dye and antibacterial activity. Heliyon 2020, 6, e04603. [Google Scholar] [CrossRef] [PubMed]
- Pallela, P.N.V.K.; Ummey, S.; Ruddaraju, L.K.; Gadi, S.; Cherukuri, C.S.; Barla, S.; Pammi, S. Antibacterial efficacy of green synthesized α-Fe2O3 nanoparticles using Sida cordifolia plant extract. Heliyon 2019, 5, e02765. [Google Scholar] [CrossRef]
- Hammad, E.N.; Salem, S.S.; Mohamed, A.A.; El-Dougdoug, W. Environmental impacts of ecofriendly iron oxide nanoparticles on dyes removal and antibacterial activity. Appl. Biochem. Biotechnol. 2022, 194, 6053–6067. [Google Scholar] [CrossRef]
- Batool, F.; Iqbal, M.S.; Khan, S.-U.-D.; Khan, J.; Ahmed, B.; Qadir, M.I. Biologically synthesized iron nanoparticles (FeNPs) from Phoenix dactylifera have anti-bacterial activities. Sci. Rep. 2021, 11, 1–9. [Google Scholar] [CrossRef]
- Wang, L.; Hu, C.; Shao, L. The antimicrobial activity of nanoparticles: Present situation and prospects for the future. Int. J. Nanomed. 2017, 12, 1227. [Google Scholar] [CrossRef]
- Gudkov, S.V.; Burmistrov, D.E.; Serov, D.A.; Rebezov, M.B.; Semenova, A.A.; Lisitsyn, A.B. Do iron oxide nanoparticles have significant antibacterial properties? Antibiotics 2021, 10, 884. [Google Scholar] [CrossRef]
- Deshmukh, A.R.; Gupta, A.; Kim, B.S. Ultrasound assisted green synthesis of silver and iron oxide nanoparticles using fenugreek seed extract and their enhanced antibacterial and antioxidant activities. BioMed Res. Int. 2019, 2019, 1714358. [Google Scholar] [CrossRef]

Disclaimer/Publisher’s Note: The statements, opinions and data contained in all publications are solely those of the individual author(s) and contributor(s) and not of MDPI and/or the editor(s). MDPI and/or the editor(s) disclaim responsibility for any injury to people or property resulting from any ideas, methods, instructions or products referred to in the content. |
© 2023 by the authors. Licensee MDPI, Basel, Switzerland. This article is an open access article distributed under the terms and conditions of the Creative Commons Attribution (CC BY) license (https://creativecommons.org/licenses/by/4.0/).
Share and Cite
Sharif, M.S.; Hameed, H.; Waheed, A.; Tariq, M.; Afreen, A.; Kamal, A.; Mahmoud, E.A.; Elansary, H.O.; Saqib, S.; Zaman, W. Biofabrication of Fe3O4 Nanoparticles from Spirogyra hyalina and Ajuga bracteosa and Their Antibacterial Applications. Molecules 2023, 28, 3403. https://doi.org/10.3390/molecules28083403
Sharif MS, Hameed H, Waheed A, Tariq M, Afreen A, Kamal A, Mahmoud EA, Elansary HO, Saqib S, Zaman W. Biofabrication of Fe3O4 Nanoparticles from Spirogyra hyalina and Ajuga bracteosa and Their Antibacterial Applications. Molecules. 2023; 28(8):3403. https://doi.org/10.3390/molecules28083403
Chicago/Turabian StyleSharif, Muhammad Shakeeb, Hajra Hameed, Abdul Waheed, Muhammad Tariq, Afshan Afreen, Asif Kamal, Eman A. Mahmoud, Hosam O. Elansary, Saddam Saqib, and Wajid Zaman. 2023. "Biofabrication of Fe3O4 Nanoparticles from Spirogyra hyalina and Ajuga bracteosa and Their Antibacterial Applications" Molecules 28, no. 8: 3403. https://doi.org/10.3390/molecules28083403
APA StyleSharif, M. S., Hameed, H., Waheed, A., Tariq, M., Afreen, A., Kamal, A., Mahmoud, E. A., Elansary, H. O., Saqib, S., & Zaman, W. (2023). Biofabrication of Fe3O4 Nanoparticles from Spirogyra hyalina and Ajuga bracteosa and Their Antibacterial Applications. Molecules, 28(8), 3403. https://doi.org/10.3390/molecules28083403










